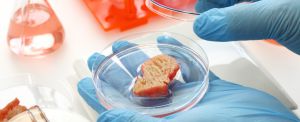

Ученые из Сербии разработали инновационные мясные продукты |
| 04.11.2025 |
![]() Группа ученых из Сербии создала новую линейку мясных продуктов, в которой значительная доля животного белка замещается растительными компонентами. Новый продукт сочетает преимущества традиционного вкуса и аромата с экологическими преимуществами растительного сырья. Благодаря внедрению инновационных технологий, ученые смогли добиться снижения себестоимости производства, сохранив при этом традиционные характеристики продукта. По словам разработчиков, использование растительных компонентов позволяет сократить выбросы парниковых газов, уменьшить нагрузку на природные ресурсы и повысить устойчивость сельскохозяйственного сектора. Замещение части животных белков на растительные также положительно сказывается на здоровье потребителей, снижая потребление насыщенных жиров и холестерина. Уже сейчас новая технология привлекла внимание крупных европейских производителей. Две крупные немецкие компании приобрели права на использование сербской разработки. Эксперты отмечают высокий потенциал технологии и ожидают, что вскоре аналогичные решения будут активно применяться и в других странах Европы. Источник: srbija.ru
|